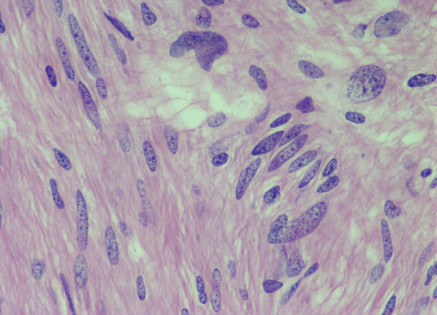

Cortesía de la Dra. Claudia Haydée Caro Sánchez, del INCAN.
Mujer de 57 años, con dolor abdominal leve de predominio postprandial. En la tomografía computada se evidenció una lesión en curvatura menor de 5 cm, dependiente de la pared. No se realizó biopsia y se programó para resección de lesión en cuña.
1.- ¿Cual es el abordaje diagnóstico por tinciones de rutina?
a) leiomioma
b) schwannoma
c) tumor glómico
d) tumor del estroma gastrointestinal.
2.- ¿Qué estudios especiales solicitarías para apoyar tu diagnóstico?
a) PS-100 y SOX-10
b) Vimentina, AAML
c) CD117, DOG-1, CD34
d) AAML, h-Caldesmona